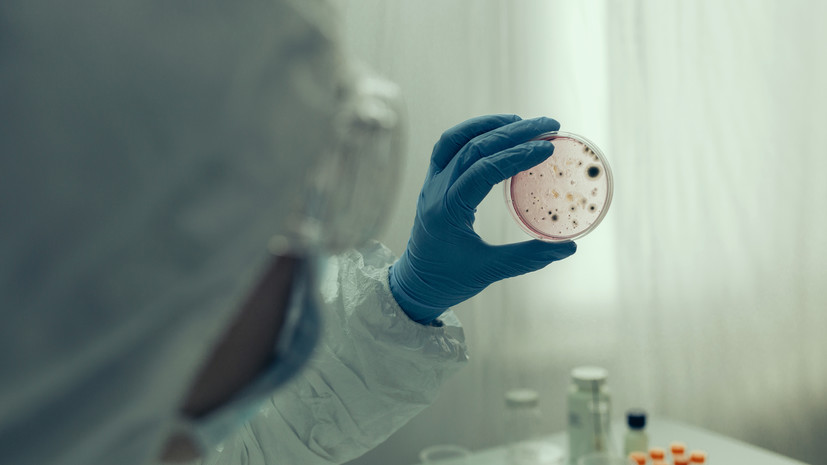
Врач Демьяновская: в России налажена система эпидемиологического контроля холеры

Что такое холера и как происходит заражение
Екатерина Демьяновская, врач-эксперт лаборатории «Гемотест», объяснила, что холера — острое инфекционное заболевание, вызываемое бактерией Vibrio cholerae. Существует два варианта возбудителя: классический и устойчивый Эль-Тор. Главная опасность — стремительное обезвоживание из-за диареи и рвоты. Заразиться можно через сырую воду, немытые продукты, уличную еду или контакт с инфицированными предметами.
Симптомы и группы риска
Инкубационный период длится от 12 часов до 5 дней. Бактерия поражает тонкий кишечник, провоцируя выделение токсина и массивную потерю жидкости. Основные симптомы: водянистая диарея до 20 раз в сутки, рвота, слабость и головная боль. Наиболее уязвимы дети, пожилые люди и пациенты с хроническими заболеваниями — их организм тяжелее переносит интоксикацию.
Современные методы лечения
«Холера — серьёзное заболевание, но паника неуместна, — подчеркнула Демьяновская. — Сегодня существуют эффективные препараты и отработанные протоколы терапии. Своевременное обращение к врачам позволяет минимизировать риски и ускорить выздоровление». Эксперт также отметила высокий уровень эпидемиологического контроля в России и достаточную гигиеническую грамотность населения.
Правила безопасности в путешествиях
При посещении стран Азии, Африки или Америки важно соблюдать меры предосторожности: пить бутилированную воду, избегать уличной еды, мыть фрукты кипячёной водой, регулярно обрабатывать руки и не купаться в непроверенных водоёмах. Эти простые правила снижают риск заражения до минимума.
Оптимистичный прогноз от экспертов
Недавние единичные случаи холеры у туристов, посещавших Индию, не повлияли на общую благоприятную обстановку. Более 300 человек в Подмосковье и Воронежской области находятся под наблюдением, что подтверждает оперативность системы контроля. Врач-иммунолог Ирина Ярцева поддержала коллегу: «Риск вспышки исключён благодаря слаженной работе медиков и профилактическим мерам».
Источник: russian.rt.com



